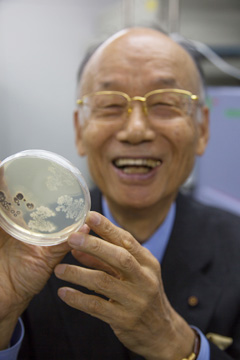
no84_interview_main_figure07

将来は村のリーダーに

山梨県韮崎市の山の中に、県下を見渡せる場所があります。子ども時代に駆けまわった山だからよく知っているんです。そのふもとに美術館を建て同市に寄贈し、温泉も作りました。故郷に恩返しがしたかったからです。私の研究人生は生まれ育ったこの土地につながっています。
1935年、韮崎市に農家の長男として生まれました。村の顔役としていつも村のために働いていた父は、私の自慢でした。例えば、今でもおいしい水が飲める村の簡易水道も、父の働きかけでいち早く引かれたものです。父はそのような仕事の話はしてくれるけれど、私にああしろこうしろとは言いませんでした。ただ野良仕事はみっちり仕込まれました。米俵を馬の背中にくくりつけるのもすっかり得意になりましたよ。お役所関係の仕事もやらされましたね。例えば田んぼ、畑、養蚕に関する手筈などです。それで中学3年生になる頃には、全ての仕事を村の青年たちと同じくらいにはやれるようになったんです。長男だから、父には自分の跡取りとしての期待があったのでしょう。
母は小学校の教師でしたが、これまた勉強しろとは言いません。ただ、よく画用紙やクレヨンを買ってくれて、絵を描くことを勧められましたね。学力よりも感性を伸ばすことを大切にしてくれたことには今でも感謝しています。母が学校で働いているあいだ私の面倒を見てくれた祖母は、口癖のように「情けは人の為ならず、巡り巡って己が為」ということわざを繰り返していました。とにかく人のために働きなさいと、常に言い聞かされて私は育ったわけです。私の人生は、祖母の教えの実践だったなあと思います。近所の人たちもずいぶん目をかけてくれました。昔は隣近所みんなで子どもを育てたものですよ。叱られたり、あるいは「よく働くね」って褒められたり。田舎でしたがとても良い教育を受けたと思います。
山梨の自宅にて家族と。南アルプスを望む村の農家に生まれた。家族からはよく仕事を言いつかったが、誰も勉強しろとは言わなかった。祖母(中列右)は人のために働くよう繰り返し教えた。(本人:前列左)

中学生のころ。勉強よりも卓球やサッカーなどのスポーツに打ち込んだ。農家の長男としてよく働き、野良仕事や役所関係の仕事は一人前にできるようになっていた。
スキーに熱中、学業は低空飛行
周りの環境もあってか勉強よりも体を動かすことが好きで、高校までサッカー、スキーのクロスカントリー、卓球といろいろなスポーツに明け暮れました。だから研究者になるなんて夢にも思わなかった。でも昔から不思議な勝負強さを持っていたようで、大学受験では山梨大学の学芸学部にポンと受かったのです。
大学時代にのめり込んだクロスカントリーは、高校のときと合わせて県下で5年連続優勝を果たしました。新潟県の妙高高原の横山隆策先生に入門して練習していたのですが、もう死ぬかと思うくらい辛い経験を何度もしました。横山先生は厳しい人でした。私が服の袖で鼻水をぬぐっていると「鼻水を拭く力があるなら、なぜもう一歩早く前へ出ないのか」と怒るんです。どんなに大変でも、目標に向かって進んでいく心構えを学んだ貴重な時期だったと思っています。
スキーから学んだことはまだあります。ひとつは、レベルの高い人達がいる環境に身を置くことの大切さ。当時一緒に練習していた選手のレベルは非常に高く、何人もオリンピック選手がいました。すると知らぬ間に、教わらなくてもあるレベルまで到達できることが分かったのです。だから山梨に帰って優勝できたわけですね。もうひとつは、人まねをしないことの大切さ。いくら優れた人に教わっても、まねだけでは結局その人を超えられない。地道に努力して、独自の方法を確立していかなくてはならないということを学びました。私の研究スタイルは、スキーで学んだ教訓に貫かれているように思います。
学業のほうはまったくの低空飛行でしたが、何でも面白がって取り組むものですから先生方には可愛がられました。当時の山梨大学にはマイスター制度という、学生が自分で選んだ担任教官の研究室に出入りして、自由に研究ができる斬新な制度がありました。私は油脂有機化学で知られていた丸田銓二朗先生のもとで、ペーパークロマトグラフィーや薄層クロマトグラフィ薄層クロマトグラフィ物質を分離・精製する方法の一つ。ガラス板の上に樹脂などを薄く塗布したもので、展開時間が短く分離能に優れているのが特徴。を使った脂肪酸の定量方法を学びました。これが有機化学との出会いです。また分野は違いますが、一緒に山に行って調査のお手伝いをした地質学の田中元之進先生のアドバイスも心に残っています。「大村くん、社会に出たらどこの大学出身だろうと関係ない。卒業して5年間が勝負だぞ」。
国民体育大会冬季大会(1957年)に出場したとき。妙高高原で厳しい訓練を積んだ。

山梨大学時代、スキーの大会で1年間に獲得したトロフィーを前に。クロスカントリーは山梨県下で5年連続優勝を果たすほどの腕前だった。

教師になって勉強のやり直しを決意
大学卒業後、幸いにも都立高校の夜間部の教師になることができました。しかし大学での成績はいま一つだったため、いざ教える立場になってみると明らかに力不足を感じましたね。こんな先生では駄目だ、もう1回勉強し直して、ちゃんと生徒に教えられるようになろうと決心し、社会人2年目にして東京教育大学(現・筑波大学)の研修生になったのです。教育大では天然物有機化学で有名な中西香爾(こうじ)先生(現・コロンビア大学名誉教授)のもとで改めて化学を勉強しました。そこでもっと本腰を入れて学びたくなり、中西先生の紹介で東京理科大学の都築洋次郎先生(元・東京理科大学名誉教授)の研究室の大学院修士課程に入学したのです。都築先生の研究室は、核磁気共鳴(Nuclear Magnetic Resonance : NMR核磁気共鳴(NMR)磁場に置かれた原子核に電磁波を照射したときに起こる、エネルギーの共鳴吸収現象。共鳴が起こるときの電磁波の強さから、原子間の化学結合の状態などを推定することができ、今日では化合物の構造解析に広く応用されている。)機器を駆使して有機化合物の化学構造を調べるという、当時としては最先端の技術を手掛けていました。幸運なことに、私はそれを用いた研究をすることになったのです。
今ではNMRは日本中で使われていますが、まだその頃は日本に1台しかありませんでした。その1台は東京工業試験場にあり、昼は試験場の研究者達が使うけれど夜なら使っていいということになったのです。徹夜で機器の設定をして、糖の立体構造の分析を始めました。それからというもの、昼間は大学で勉強、夜は高校に行って授業をし、土日は徹夜で実験という毎日。資金が足りない時はアルバイトで時間講師もやりましたよ。ちょうどこのころ弟が東京大学に受かり、東京にいるなら弟の面倒くらい見ろと父に言われて、弟が卒業するまでの4年間かなり支援もしました。結局、社会に出てから修士号を取るまでに5年かかりましたが、そこで身に付けた化学の知識と技術が、私の研究の基礎になっています。特に化合物の構造決定に自信をもつことが出来たことは、後に強力な武器となりました。まさに田中先生の「卒業して5年間が勝負」という言葉通りになったんです。

東京教育大学に通い始めたころ。夜は高校で授業をして、昼間は中西香爾先生のもとで勉強をした。

大学院時代、日本にまだ1台しかなかったNMR機器の前で。真夜中に実験を行って、有機化合物の構造解析法を身に付けていった。

都築研究室の講師・森信雄先生と。大学院時代、実験や論文の書き方を指導してくれ、英語で学術論文を書くことができた。(本人:右)
化学者が微生物に出会う
1963年、修士号を取ったその年に山梨大学工学部発酵生産学科の加賀美元男先生の研究室の助手になりました。山梨大学時代の恩師の丸田先生が用意してくれたポストです。加賀美先生はワイン醸造の研究をしていました。私は発酵途中のワインに含まれる糖の分析を担当して、酵母がブドウ糖を一夜にしてアルコールに変えてしまう働きを目の当たりにし、微生物に魅せられてしまいました。それ以来微生物の虜になっているわけです。
1965年、微生物研究の刺激的な環境を求めて北里研究所北里研究所破傷風菌の純粋培養に成功し、その抗体を発見した北里柴三郎によって1914年に創設された日本初の私立医学研究所。ペスト菌、赤痢菌の発見や梅毒の薬サルバルサンの発見など感染症治療の研究で多くの実績を挙げ、日本の医学に大きく貢献した。に移りました。感染症の研究で世界に冠たる研究機関です。感染症治療に使う抗生物質は、本来は微生物が自己防衛のために生産すると考えられている有機化合物で、アオカビから発見されたペニシリンが有名です。抗生物質は当時すでに広く使われていましたが、多くの場合その詳細な化学構造は分かっていませんでした。だからどうして効くのかという生化学的なメカニズムの解明も遅れていたのです。私は構造決定が得意だったものですからとても重宝されました。秦藤樹所長(元・北里大学理事長、学長)の指示で最初に構造を決定したのはロイコマイシンという化合物で、抗生物質としてすでに使われていたものです。この研究は10成分を単離して構造を決めるというものでしたが順調に終わり、セルレニンセルレニンセルレニンの構造式。
という抗カビ性を持つ物質の単離と構造決定を行いました。そしてその構造から、これには脂質の生合成を阻害する働きがあるのではないかと思ったのです。化学の出身でしたから、構造を見てピンと来たのです。共同研究者と確かめてみるとその通りで、脂肪酸の生合成を阻害する物質としては世界初の発見になりました。これは、のちに留学先での共同研究に発展していきます。

北里研究所に来てどんどん論文が出るようにはなったのですが、ここで考え込みました。化合物の構造決定は、人が苦労して見つけた化合物があってはじめて成り立つ仕事です。化合物を微生物の中から見つけ出すのは大変な作業なのです。自分は楽な仕事をしているだけではないかと思い始めたわけです。そこで一念発起、自分の手で有用な化合物を探し出して構造決定までやろうと決意しました。専門は化学ですが、山梨大の助手時代に微生物を扱った経験もあったので何とかなるだろうと、まず取り組んだのがスクリーニング方法(目的のタイプの化合物を検出する方法)の確立です。当時はとにかく抗生物質を見つけ出そうという研究が主流でした。しかし、微生物が生産する化合物は限りなく多様に違いない。その一つ一つが役割を持って産み出されているのだから、抗生物質以外にも有用な物質がたくさんあるはずだと私は考えました。人間がそれを調べる方法を持っていないだけだと思ったのです。そこで目標を抗生物質に限らず、様々なタイプの化合物を検出するスクリーニング方法を導入していきました。最初に、呈色試薬を使って塩基性の有機化合物を検出するスクリーニングを試みました。幅広い物質を検出できる方法を使って、微生物が作る多様な化合物をまず見てみようと思ったのです。採れた化合物の化学構造を調べておけば、その働きを推定するのに役立ちます。この方法で見つけたスタウロスポリンという物質は、プロテインキナーゼプロテインキナーゼ酵素の一種で、ATPのリン酸基をタンパク質へ転移させる反応を触媒する。リン酸化されたタンパク質は立体構造や荷電状態が変化し、酵素活性などが変化する。細胞の遺伝子発現や細胞周期などをコントロールする役割を担っている。を阻害する働きを持つことが後に分かり、研究試薬として世界中で使われています。またグリーベック®など、現在臨床で使われているいくつかの抗癌剤開発の基礎化合物にもなっています。生きた特異な動物細胞を使ったスクリーニングを、初めて試みたのも私の研究室です。がん化したマウスの神経芽細胞を使う方法で、神経芽細胞に樹状突起を作らせるよう誘導する物質を探しました。それで見つけたのがラクタシスチンです。これは、田中啓二先生(公益財団法人東京都医学総合研究所所長)達が発見された、プロテアソームプロテアソーム細胞内の不要なタンパク質を分解する巨大な複合体酵素。田中啓二博士らによって発見・命名された。の阻害剤であることが分かりました。これも世界的な研究試薬となり、ノーベル賞受賞者を含む多くの研究者がこれを使って研究を進展させました。
当時、抗生物質の専門家は医学、微生物学出身の人が主でしたが、私は化学の出身でしたので、化学と微生物学の両方を巧みに利用してきました。人まねをしないでたどり着いた結論です。最初の一歩を踏み出すよう目指したのは、スキーから得た教訓ですね。
展望を求めてアメリカへ
1970年代に入って国内での研究に限界を感じ始めていたころ、私をかわいがってくれた抗生物質学術協議会(現・(公)日本感染症医薬品協会)の常務理事・八木沢行正先生のすすめがあり、留学を決めました。先生はカナダやアメリカの抗生物質界の大家をリストし、推薦状まで持たせてくれたのです。1971年3月、受け入れ先を探すために、カナダ・アメリカのいろいろな大学で講演をして回り、帰国後そのうち5つの大学に手紙を出しました。その中でアメリカ・コネチカット州のウェスレーヤン大学のマックス・ティシュラー先生が真っ先に電報で返事をくれたのです。ただしそこで提示された給料が一番安かった。他の大学もいろいろな条件で受け入れる返事をくれたのですが、ティシュラー先生の額は、一番高いところのわずか半分だったのです。妻は一番高いところがいいと言いましたが、このような条件を出してきたからには給料以外の何かがあるのではないかと思ってそこに決めました。いざアメリカの研究室に行ってみると、好きな研究ができる客員教授のポストが用意されており、キャンパス内の立派なドミトリーまで提供してくれたのです。日本の若い研究者が留学しても、教授の下働きをして帰ってくるのが関の山という時代でしたから、これは破格の待遇ですよ。さらに、アメリカで研究をスタートした途端、ティシュラー先生がアメリカ化学会の会長に就任したのです。アメリカ化学会といえば世界最大の学会(会員数:161,000人)です。その仕事に忙殺されて研究する時間もないものですから、研究費はお前が使っていいと言ってくれたのです。それで学生を指導しながら数えきれないくらいの論文を書きました。ティシュラー先生の研究室を選んで大正解だったわけです。

マサチューセッツ工科大学のアーノルド・ドメイン (Arnold Demain)教授と。留学の受け入れ先候補として、かつて講演をしに行った先生の一人。(本人:左)

アメリカ留学時代の恩師、マックス・ティシュラー(Max Tishler)先生と。自由に研究できる環境を整えてくれたたけでなく、メルク社との共同研究の橋渡しをしてくれた。(本人:左)
世界で最もハイレベルな環境で
ウェスレーヤン大学の研究環境は当時、世界最高レベルでした。化学界の大物だったティシュラー先生のもとにはそうそうたる研究者が集まり、驚きの連続でした。大きな出会いは、ハーバード大学のコンラッド・ブロック先生とのものです。ある時ファイザー製薬の友人ウォルター・セルマー氏が、「ブロックが来るけど会ってみないか」と声を掛けてくれました。ブロック先生といえば脂肪酸の生合成でノーベル生理学・医学賞を受賞した世界的権威です。ファイザー社でお目に掛かり、緊張しながらもセルレニンの話をして「脂肪酸の生合成を阻害する物質としては世界初だと思う」と言ったところ、彼は身を乗り出しました。「それが本当なら大変なことだ」。早速セルレニンのサンプルを送ると3ヶ月後にはもう作用機序を調べ、「確かに君の言う通りだ。すぐに共同研究を進めよう」と言ってきました。セルレニンは脂肪酸の生合成の過程に不可欠な縮合酵素、β-ケトアシル-CoA合成酵素に結合して、その働きを阻害することが分かりました。この発見についてブロック先生と北里研究所の野村節三氏と共同で論文を発表したところ、世界中からワァーッとサンプルの請求がありました。結局、セルレニンは医療用の薬にはならなかったのですが、今でも脂肪酸の生合成を阻害する唯一の研究試薬として世界中で使われています。

来日したコンラッド・ブロック(Konrad Bloch)夫妻と。留学時代ブロック先生とは、セルレニンの作用機作について共同研究を行った。(本人:右端)
産学連携で生まれた奇跡の薬
アメリカでの客員教授は3年の予定でしたが、できれば当分アメリカに残って、このまま良い環境で研究を続けたいと思っていました。しかし留学して1年2ヶ月で、北里研究所より帰国するようにとの連絡が来たのです。上司の秦先生が退職するので、研究室を引き継いでほしいとのことでした。日本に帰っても潤沢な研究費などあるわけがなく、まともな研究ができるとは思えません。アメリカから研究費を持って帰ろうと思い、国の研究所(NIH)やいくつもの製薬会社を回って共同研究を呼びかけました。
企業を説得するために、次のようなしくみを提案しました。まず企業から研究資金の支援を得て、有用な化合物を見つける。そして発見した化合物の使用権を企業に渡す。企業がその化合物を実用化・販売したら、その売上に応じて特許料を私の研究室に入れてもらうというものです。話をした製薬会社は全てオーケーしてくれましたが、提示された研究費の額はまちまちでした。提携先を迷っていたところ、ティシュラー先生が研究所長をしていた大手製薬会社のメルク社と話をつけてくれて、年8万ドルという高額の研究費が提供されることになったのです。当時の日本では考えられない額でしたね。メルク社がこれほど私に期待を寄せてくれたのは、これまでの私の業績に加えて、相手にもこちらにも利益のある連携のしくみを提示できたからでしょう。このとき考えたしくみは、いつしか「大村方式」と呼ばれ、産学連携の先駆けと言われるようになりました。

当時、下火になったとは言え日本は学生紛争の時代で、企業と大学が共同研究をするのはタブーだという雰囲気がありました。しかし、人の役に立つ薬を探すためには大学と企業が手を結ぶことが不可欠と考えていましたから、日本で堂々とメルク社との共同研究をスタートさせました。私の研究室は微生物の採取、化合物のスクリーニングやin vitroでの評価を担当し、メルク社が動物実験 (in vivo)を担当する、といった具合に作業を分担しました。帰国当時の私の研究室は4、5人しかスタッフがいなかったものですから、メルク社が何十人という人手をかけて動物実験や化学合成を行ってくれたのは本当に助かりました。企業と連携すべきだと考えたのは、そういう利点もあってのことなのです。
実はヒト用の薬は競争が激しいので家畜などの動物薬にターゲットを絞りました。帰国してからはとにかく契約書を作成するのに苦労し、契約が成立してからはまたこの内容を果たすのに必死でした。スタッフはつねにビニール袋とスプーンを持ち歩き、あらゆるところで微生物を採取しました。こうして発見された化合物がエバーメクチンエバーメクチン放線菌Streptomyces avermectiniusが生産していたエバーメクチンの構造式

です。静岡県・伊豆のゴルフ場に隣接した場所の土からとれた微生物が産生していたもので、家畜の寄生虫に劇的な効果を示すのです。私たちと討論の結果、メルク社の研究者がこれを化学変換してイベルメクチンにして、動物薬として売り出しました。これが世界の動物薬で売り上げナンバーワン、メルク社の全薬品中の売り上げでも2位になりました。動物薬がヒトの薬より売れたわけです。イベルメクチンは寄生虫に特異的に作用する神経毒神経毒 イベルメクチンが寄生虫の神経毒として働くメカニズム。正常な神経伝達の場合、シナプス前膜より放出される神経伝達物質(グルタミン酸)が、シナプス後膜の塩化物イオンのチャネルに結合してチャネルが開き、細胞外からイオンが流れ込み細胞内外の電位差に変化が生じる(下図右)。イベルメクチンはこのチャネルに作用して開いたままにしてしまう(下図左)。チャネルにイオンが流れ込んだままの状態になり、神経伝達物質が結合しても電位差に変化が生じなくなる。

であることが分かりました。線虫やダニなどの寄生虫の神経伝達を担うシナプスシナプス神経細胞間、あるいは神経細胞と筋肉などの間の接合部位。の後膜に、グルタミン酸で作動する塩素イオンのチャネルがあります。イベルメクチンが作用するとそのチャネルが開いたままになり、塩素イオンが自由に出入りし続けるので、神経伝達ができなくなるのです。同じようなシナプスは宿主である動物の脳にもありますが、幸い脳関門脳関門脳の血管内に形成され、血液と間質液の間の分子の移動を調節する部位。によってシャットアウトされ影響は出ません。だから寄生虫だけに効くのです。その後この化合物がヒト用の薬品としても使えることが分かってきました。ヒトへの応用に際しては、動物薬としての膨大な実績がそのまま、動物実験以上のエビデンスになりました。こうして成果を挙げていったおかげで、当初3年の予定だったメルク社との共同研究契約が20年も続いたのです。
私の研究チームが発見した化合物はこれまで500近くになり、そのうち26種類は医薬、動物薬、研究用試薬などとして実用化されています。来年認可予定のものがもう1つあります。学術論文も1000を超えました。見つけた化合物一つ一つに思い出があります。私たちが見つけた化合物を全て記載した本を作り、希望する世界中の研究者に無償提供しています。本のタイトルは「Splendid gifts from microorganisms」(微生物からのすばらしい贈り物)ですが、化学界では「イエローブック」という呼び名で通っています。この本の中に欲しい化合物があれば、分与したり、私たちと共同研究できるようになっているのです。こんな本は世界に一つしかありません。目次には化合物の名前がずらりと並んでいます。ディヴィッド・ホップウッドという、世界で初めて遺伝子操作で新しい化合物を作り出すことに一緒に成功した親しい研究者がいるのですが、彼が何年か前に「大村たちが見つけた化合物のイニシャルは、アルファベットあと数種類でAからZまでそろう」と指摘してくれまして、その後、実は「ウィッケロール(Wickerol)」を最後に全てのアルファベットが揃いました。これで、うちで発見した化合物の辞書ができあがったわけです。でも私達が発見した化合物は微生物が作っていたものなのです。だからそれを見つけたからって、あまり自慢するほどのことではないなと秘かに思っています。一方、私たちの発見が様々な分野を発展させるきっかけを作ったという点では、人類に貢献したと思ってもいます。
東京教育大学時代に化学を学んだ恩師の中西香爾先生と。(本人:右)
ハーバード大学にてブロック先生(左)と、有機合成でノーベル化学賞を受賞したイライアス・コーリー(Elias J. Corey)博士(右)と。コーリー博士はラクタシスチンの合成にいち早く成功し、その活性本体を「オオムラライド」と名付けてくれた。

ヒトパピローマウイルスの発見でノーベル医学・生理学賞を受賞したハラルド・ツール・ハウゼン(Harald zur Hausen)博士と。(本人:右)

立体化学の先駆者としてノーベル化学賞を受賞したデレック・バートン(Sir Derek Barton)博士と。(本人:右)

これまで見つけた化合物とそれを生産する微生物、そしてそれらの生物活性を記載した本。通称「イエローブック」。
富士山の麓のホテルにて、微生物遺伝学のディヴィッド・ホップウッド(David Hopwood)教授と。彼との共同研究によって、1985年放線菌の遺伝子組み換えで新しい化合物を生産することに世界で初めて成功した。(本人:左)
国際学会で集まった研究者仲間を自宅に招いて、ホームパーティを開いた。背後には初めて購入した鈴木信太郎氏の洋画が見える(本人:前列中央)。
研究の柱は人材育成
有用な化合物を探索する研究は、微生物を採取する人、分類する人、化合物を抽出する人、アッセイアッセイ
バイオアッセイ。生物に作用のある化合物を生体に与えて、それに感応する生物の反応からその化合物の性質、効力、構成成分などを推定する方法。する人など様々なプロセスを受け持つ人が必要で、彼らのチームワークが重要です。誰か一人がつまずくと、連携がうまくいきません。例えば、せっかくいいものを微生物が作っていても、検出する係が怠けていれば見つからないでしょう。私の役割は、一人ひとりの能力を見極めて、チームを組織することです。そのための柱にしたのは人材育成です。はじめに目標を決めて、こういう風にやったらどうだと言って励ましてやり、ゆくゆくはみんな一人前になるように育てるんです。皆が自立して研究できるようになると、自然と人間関係も良くなります。うちのグループでこれまで120人近くが博士号を取り、そのうちの30人が教授になっています。私立大学でそれだけの人材を育てた研究室はなかなかないと思いますよ。
化合物探しは、それぞれが気の遠くなるような作業を続けるわけですから、一人ひとりのモチベーションを保つための配慮も必要です。一緒にやっているスタッフの様子は今でもちゃんと見ていますし分かっています。若い人たちを励ましたり、落ち込んでいると飲みに連れて行ったりもします。時には嫌な役回りもやりますよ。誰かがちょっと怠けていると頑張れよと言ったりね。いま私のグループには教授が4人いて、全体を合わせると約60人の研究員が研究していますが、皆がそれぞれの持ち場できちんと仕事をして、なおかつ発展させていけるように気を配っています。それで有用な化合物が見つかれば、それぞれの分野で研究者自身の業績として発表できるわけですから。今の私の役職は「スペシャルコーディネーター」です。こんな肩書は名刺には書いていませんけれど。論語に「君子は器ならず」という言葉があります。リーダーは自分の領域のことしか知らないというのでは駄目だ、広い視野を持てという意味です。こういう立場にあるとき、思い出すのは父のことです。父は村のリーダー的な存在でしたが、本当に周りに気を配っていました。私はその背中を見て育ちましたから。
これは臨済宗の僧侶・松原泰道松原泰道(1907〜2009)
臨済宗・龍源寺住職。早稲田大学文学部卒。文筆家としても知られ、100冊を超える著書を残した。代表作「般若心経入門」は仏教書ブームの火付け役となった。さんの本で学んだことですが、源氏物語の光源氏が息子の夕霧の成長をうながすために、他家に預けるとき「夕霧の経営をあげてお願いします」と言うのです。つまり経営という言葉は人材育成という意味である。それで私は研究を経営するという言葉をよく使うようになりました。経営の研究ではなく、研究の経営です。これには4つの要素があります。まずアイデア、こういうものが必要だという研究のアイデアを出すこと。次にそのための資金を導入すること。それから人材育成を行うこと、これが非常に重要です。最後に得られた成果の社会還元。この4つがそろってはじめて、研究を経営したことになるというのが私の考えです。


グラブス触媒の発見でノーベル化学賞を受賞したロバート・グラブス(Robert Grubbs)教授と。北里研究所で私たちが主催したシンポジウムに招いた。後進たちがレベルの高い研究者と交流できるよう配慮している。(本人:右)

不斉触媒反応でノーべル化学賞を受賞したバリー・シャープレス(Barry Sharpless)教授と。私たちが主催する“Kitasato Microbial Chemistryセミナー”に招き、「次にノーベル化学賞を取るとしたらこの人だ」と学生達に紹介した。10日後、シャープレス教授はノーベル賞を受賞した。(本人:左)
研究の経営から病院の経営へ
研究と並行して、旧社団法人北里研究所の財政を立て直す仕事もやりました。実は研究所の財政は破綻寸前どころか、実質的には既に破綻していたのです。研究所の監事になったときこのことに気付いて、北里をこのまま放っておいてはいけないという気持ちから意見書を提出しました。北里研究所が創設した(学)北里学園・北里大学がどんどん大きくなって、研究所から資金も資材も持っていったのに研究所を蔑ろにし始めたのが一因です。私はそれまで9年間北里大学の教授でしたが、北里大学の教授の席は辞して、副所長として研究所に乗り込みました。大学の教授に落ち着いてやっと給料もちゃんと入るようになったのに、また給料の安い研究所に戻るなんて、と妻はぼやきましたよ。でも自分の給料のことなんて考えていたら大きな仕事はできません。貧乏研究所の副所長に専念して財政改革に取り組み、3~4億円の赤字だったところを金融資産230億円以上の黒字にまでしたところで、北里学園・北里大学と統合しました。この時、「学校法人北里学園」を「学校法人北里研究所」に改称し、北里柴三郎先生が創設した歴史ある「北里研究所」を法人名にしたのです。

世の中、どうやってお金を得るかに関心が集まりがちですが、入ったお金をどう使うかが大事なことです。私はイベルメクチンで得た特許料で病院を建てました。世界中訪ねても、特許料で病院をつくった大学の先生というのは私だけかもしれません。私は医者ではないので、医師会との意見調整は本当に大変でした。1994年、大変な苦労ののち埼玉県北本市の自然豊かな土地に440床の総合病院を作ることができました。新しい病院には、これまでの病院にはない工夫をしました。幼いころから絵が好きで絵画を収集していたので、病院の待ち時間に絵が見られるといいなと思い、絵を展示することにしたのです。エントランスや待合室には美術館よりすごい絵が掛かっていますよ。ニューヨークで活躍した抽象画の岡田謙三氏岡田謙三(1902~1982)日本を代表する抽象画家。戦後アメリカに渡って抽象表現に出会い、アメリカ画壇を拠点として活躍。抽象表現に、日本的な自然観(幽玄)を導入した「ユーゲニズム」と呼ばれる独自の世界を確立した。や洋画の鈴木信太郎氏鈴木信太郎(1895~1989)洋画家。リズミカルなタッチと穏和な色調が特徴。80年に渡って創作を続け、日本の洋画界に大きく貢献した。をはじめ一流の作家の作品が集まっています。半分以上が寄付やコンクールで集まった作品で、「絵のある病院」という理念に多くの方が共鳴してくださったおかげです。これは日本における本格的ヒーリング・アートの先駆けだと言われます。
北里研究所構内にて、秦藤樹先生(左端)、ペニシリンの研究でノーベル生理学・医学賞を受賞したエルンスト・ボリス・チェイン(Ernst Boris Chain)博士(中央)らと。右手にはコッホ・北里神社がある。(本人:右端)
社会貢献と教育の喜び
イベルメクチンは人の線虫性感染症の薬としても利用されるようになりました。線虫症で最も深刻なものはオンコセルカ症とリンパ系フィラリア症です。幸い日本では撲滅されていますが、熱帯地方を中心に、世界の人口の20パーセントはリンパ系フィラリア症の感染の危機にあり、1億何千万人という人がすでに感染していました。オンコセルカ症はアフリカを中心に年間数千万人が感染していると言われ、重症になると失明を引き起こします。現在メルク社が年間約3億人分のイベルメクチンを無償で提供しており、あと10年でこれらの熱帯病は撲滅できると言われています。イベルメクチンが撲滅を可能にする理由は、薬の摂取が年に1回でよく、アフリカなど貧しい地域の人たちにも行き渡るためです。もう一つは、少量で効果があり副作用がなく、よほどの過剰投与をしない限り人体に影響を及ぼすことがないためです。だから集落の人が1日か2日講習を受ければ、看護師や医者でなくても地域住民に投与できるのです。今では年一回、WHO(世界保健機構)の指導でアフリカの1万2,000集落にイベルメクチンが行き渡るようになっています。そして各集落の代表者が一人一人に配っていくのです。今ではビタミン剤なども同じシステムで行き渡らせるようになっています。これもまた、最初の一歩を踏み出した功績かもしれません。
現在イベルメクチンによって2,000万人分の食料確保ができるようになったと言われています。線虫症で目が見えなくなったり歩けなくなったりすると、働けず経済的な打撃になります。イベルメクチンが彼らを働けるようにしたことで、食糧の増産にも貢献しているのです。今の子どもたちはもう感染症を知らない世代で、失明することも足が腫れ上がることもありません。2014年、世界の保健に貢献したという功績でガードナー国際保健賞ガードナー国際保健賞2009年にカナダのガードナー財団によって制定され、途上国の人々の保健に大きな貢献を果たした科学者に贈られる賞。をいただきました。遠い国の感染症の特効薬を日本に住んでいた微生物が作っていて、それを私の研究チームが見つけた。興味深い話でしょう。

最近もっとも力を入れているのは人材育成で、あらゆる場面でそれを考えながら仕事をしています。一番大事なのは感性、想像力を育むこと。芸術に進むにしろ科学に進むにしろ、そこから独創性が生まれます。そして想像力は思いやりの心を育みます。論語で「己の欲せざるところは人に施すことなかれ」といいますが、他人の心を想像する力が思いやりにつながるのです。いま私が理事をしている女子美術大学の付属高等学校が2015年で100周年になるので、記念に何か催しをと考えていますが、女性や子どもたちは発想が面白い。やっぱり絵が好きだというのはいいことですよ。アッと驚くような発想をしますから、そういう芽を伸ばしたいと思っています。
故郷への恩返しになればと思って、山梨県にも色々なものを創設しました。ひとつは「山梨科学アカデミー」。山梨県の科学の振興、科学教育の充実を目指して創設したもので、2015年で20周年を迎えます。研究者の交流会や講演会、顕彰を行ったり、県下の小中学・高等学校で「未来の科学者訪問セミナー」という、アカデミー会員による講義を行っています。1995年に創立以来、講義を受けた児童・生徒の数は3万5千人を上回ります。もう一つは温泉と韮崎大村美術館です。学生時代に学んだ地質学の知識を生かして自宅の敷地内に温泉を掘り、「白山温泉」と名付けた温泉施設を作りました。地域の活性化に繫がれば、と思っています。一方その隣接地に、私が40年余り収集してきた女流作家を中心とした2,000点余の絵画や陶器を展示する韮崎大村美術館を建設し、収蔵品と共に韮崎市に寄贈しました。こちらもぜひ見てほしいです。そういうわけで、今は自分のことではなく周りが育つことを楽しみに仕事をしています。

スイス・ジュネーヴにて。WHO本部の玄関前には、オンコセルカ症撲滅運動のシンボル「盲目の人を導く子」のブロンズ像が建てられている。

オンコセルカ症の撲滅運動を開始したWHOのエイブラハム・サンバ(Ebraham Samba)博士と。(本人:左)

サンバ博士がプレゼントしてくれた、小さな「盲目の人を導く子」の像。サンバ博士は、「オンコセルカが撲滅されたら、この像はゴールドの価値に変わるぞ」と言ってくれた。
アフリカのガーナの小学校で、子供達に向かって自己紹介をした。イベルメクチンのことを話したところ歓声が挙がった。
アフリカの子供たちと。
サイエンスは一期一会
線虫の発生学でノーベル生理学・医学賞を受賞した友人のシドニー・ブレナー先生の自伝『マイライフ・イン・サイエンス』の中にこんな言葉があります。「科学を飛躍的に進歩させるのは他の分野からやってきた人間だ」。私は化学の分野から、しかも全く抗生物質の勉強もしないで飛び込んだ。でも化学の視点があったからこそ、微生物が作り出す物質の豊かさに気づくことができた。そういうところが良かったのだと思っています。
研究にはラッキーな面も必要だと思います。至誠天に通ず、という言葉がありますが、一生懸命やれば天が分かってくれて、運を呼ぶ気がするのです。私は非常なラッキーマンです。メルク社から研究費がもらえたのも、良い人たちに巡り合えたのも、故郷で良い教育を受けられたのも、すべてラッキーだったと思っています。そうやって周りが私をうまい具合に持っていってくれるのだから、幸せですよ。そこで大切にしているのは「一期一会」、日本の茶の湯の精神です。この人とはもう二度とお会いできないかもしれないと思って、全力で出来るだけのことをして差し上げるのが「一期一会」の心です。科学者同士だってサイエンスだけの間柄ではなく、全てを総合してお付き合いすることが大事でしょう。だから人間として自分を磨いていかなくてはならないのだと、私は若い人達に言いますし、人に言うからにはちゃんとやってみせなければいけないと思っています。実践躬行(きゅうこう)実践躬行理論や信念などを、口で言うだけでなく、実際に行動によって示すこと。ですよ。

趣味はゴルフ。エバーメクチンの生産菌もゴルフ場の近くの土から見つかったので、「ゴルフのついでに採取したのか」と冗談交じりに聞かれることがある。














